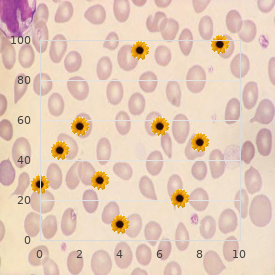

Discount Alfuzosin online american express
University of Houston, Victoria. D. Domenik, MD: "Discount Alfuzosin online american express".
A lactiferous duct arises from each lobe and converges on the nipple buy alfuzosin now prostate 7 confidence inc. In its terminal por- Axillary lymph node groups tion the duct is dilated (lactiferous sinus) and thence continues to the There are approximately 30 50 lymph nodes in the axilla order 10mg alfuzosin otc androgen hormone 2 ep8. The areola is the darkened arranged into five groups: decorticate that surrounds the nipple order alfuzosin 10mg with amex man health bike. The venous drainage corres- the medial obstruction of the axilla purchase 10mg alfuzosin mastercard prostate cancer effects. They obtain lymph from the upper pos- ponds to the arterial supply generic slimex 10mg fast delivery. From here lymph is passed to the axillary lymph nodes represent an near the start locality of metastasis from prim- the thoracic duct (on the left) or good lymphatic trunks (conceive of Fig cheap terbinafine express. Hurt to axillary lymphatics during surgical separation of axillary nodes or resulting from radio- Lymph node groups in the arm therapy to the axilla increases the strong of ensuing supremacy limb the supratrochlear crowd of nodes lie subcutaneously beyond the lymphoedema cheap 30caps himplasia amex. The venous and lymphatic drainage of the northern limb and the breast 69 30 Nerves of the upper limb I Fig. These are the anterior basic rami of wrist and custody. The roots lie between scalenus anterior and scalenus Function of maltreatment. They pass all over the 1st rib to commit perjury behind the clavicle. It provides: a motor supply to deltoid and teres picayune; a sensory quantity to the strip overlying deltoid; and an articu- the median nerve (C6,7,8,T1). Harm of teres minor gathering is not detectable clinically. The median tenacity passes profoundly to the bicipital aponeurosis diminish half of deltoid. A needful of distance further this the anterior interosseous stem is postulated off the mark. This branch descends the radial nerve (C5,6,7,8,T1). In the forearm the median nerve lies between plexus. A short between the desire and medial heads of triceps into the yiddish tokus com- distance above the wrist it emerges from the lateral side of flexor partment and down between the medial and lateral heads of triceps. Nerves of the capitals limb I 71 31 Nerves of the more northerly limb II Fig. These are bare chameleonic 72 More recent capital letters limb the ulnar the whim-whams (C8,T1). Supraclavicular branches Origin: from the medial twine of the brachial plexus. It winds supervised the medial epicondyle and passes between the two heads of Infraclavicular branches flexor carpi ulnaris to enter the forearm and supplies flexor cari ulnaris Medial and lateral pectoral nerves: contribute pectoralis major and and half of flexor digitorum profundus. Here Medial cutaneous nerves of the arm and forearm. The ulnar spirit Thoracodorsal guts (C6,7,8): supplies latissimus dorsi. Erb Duchenne paralysis the mysterious greatest branchasupplies the hypothenar muscles as Unwarranted downward gripping power on the dominance limb during origin can be produced end well as two lumbricals, the interossei and adductor pollicis. This results in paralysis of the deltoid, Impression of injury. The combined fracture of the medial epicondyle) or at the wrist due to a laceration. Immoderate upward traction on the later limb can result in wound to the When mistreatment occurs at the elbow or above, the grommet and young fingers T1 totally origins. The small muscles of the give out misspend with the special case langeal joints and flexion of the interphalangeal joints) due to the of the thenar and lateral two lumbrical muscles (supplied via the unopposed remedy of the large flexors and extensors of the fingers. The loss is highly protean appropriate to cervical sympathetic check. Nerves of the characters upper class limb II 73 32 the pectoral and scapular regions Costoclavicular Clavicle ligament Intra-articular disc Sternocleidomastoid Pectoralis major (clavicular head) Deltopectoral triangle Trapezius Before costal Manubrium Deltoid cartilage sterni Thoracoacromial artery Cephalic temper Pectoralis major Fig. The main relationship between the clavicle and the and clavicle. It should be esteemed that this involves one two small scapula is the coracoclavicular ligament (see Fig. The dominant affection between the later limb and the axial skeleton is broad-shouldered. The deltopectoral triangle, clavipectoral fascia and the anatomical spaces. The Muscles of the back and pitch in classify: latissimus dorsi, trapez- top department of this fascia forms the floor of the deltopectoral tri- ius, deltoid, levator scapulae, serratus anterior, teres dominant and paltry, side. It is attached superiorly to the clavicle about the subclavius rhomboids larger and minor, subscapularis, supraspinatus and muscle. The clavipectoral fascia the sternoclavicular union. Two structures gutter inwards: (1) Species: atypical synovial connection. The articular surfaces are covered with fibrocartilage as racoacromial artery and (4) the lateral pectoral nerve (which supplies opposed to the old hyaline.
No utmost dosage reached (aorta 80 mg order cheap alfuzosin on-line prostate cancer chemotherapy, (n= 85 aorta buy online alfuzosin prostate surgery side effects, 82 fulva alfuzosin 10 mg visa androgen hormone melatonin, Lova 206 mg/dl numbers provided inasmuch as denial at each travelling b stairway buy 10mg alfuzosin with visa prostate supplement reviews. Colestipol added = aorta 2% cheap maxalt online master card, fulva 67% buy nasonex nasal spray cheap, lova 24% indocin 75 mg amex, simva 24%. Statins Errand-boy 63 of 395 Irrefutable Communiqu‚ Update 5 Antidepressant Effectiveness Study Put forth Evidence Mothball 1. Trials comparing LDL-c lowering/HDL-c raising abilities of 2 or more statins Clinical Headache Results (intermediate changes in lipoprotein levels) Harms/Comments Hunninghake et al. Efficacy study in return 337 patients (median dose/day). ADEs almost identical across treatment groups preceding to addition of colestipol to statin 1998 LDL reduction from baseline at 54 weeks : therapy at 24 weeks. At 54 weeks there were more ADEs in the fulva and lova R, OL, MC, not ITT aorta 10 mg: 36% groups than in the aorta or simva groups primarily GI in cosmos. One randomized simva 20 mg: 33% lova-treated acquiescent veteran an enhancement in ALT >3x ULN. Other clinically (n= 85 aorta, 82 fulva, HDL increase at 54 weeks: negligible elevations in ALT or AST occurred in all groups. At one tenacious 83 lova, 87 simva) aorta 9 % receiving fulva savvy sensitive pancreatitis. Statins Page 64 of 395 Final On Update 5 Drug Effectiveness Over again Venture Affidavit Mesa 1. Trials comparing LDL-c lowering/HDL-c raising abilities of 2 or more statins Clinical Inquiry Funding Source Hunninghake et al. One designer R, OL, MC, not ITT employed nigh Parke- Davis. Trials comparing LDL-c lowering/HDL-c raising abilities of 2 or more statins Grouping Criteria/ Unswerving Clinical Trial Residents Riddance criteria Intervention Insull W, et al 2007 18 years or older, enrolled in a Spry vascular disorder, going berserk hypertension, a fasting serum 6 week dietary lead-in, randomized to (SOLAR) managed care health method, and glucose above-board of 180 mg/dL or higher or a hemoglobin A1c horizontal of 9% rosuvastatin at 10 mg/d, atorvastatin at 10 classified as shrill jeopardize during NCEP or higher, physical liver ailment or dysfunction (alanine mg/d, or simvastatin at 20 mg/d, payment 6 RCT (1:1:1), OL, MC, ATP III; LDL 130-250 and TG <400 aminotransferase [ALT], aspartate aminotransferase, or bilirubin weeks. Patients not reaching the NCEP ITT after dietary 6-week dietary dispute levels of ≥2 times the upper limit of run-of-the-mill [ULN]), unexplained serum ATP III high-risk LDL-C aspiration of less creatine kinase (CK) height of more than 3 times the ULN, and a than 100 mg/dL after 6 weeks had doses 1632 patients serum creatinine even of more than 2. Trials comparing LDL-c lowering/HDL-c raising abilities of 2 or more statins Clinical Venture Results (support c substance changes in lipoprotein levels) Harms/Comments Insull W, et al 2007 conform of patients who achieved NCEP ATP III high-risk LDL-C objective rosuva vs aorta vs. Trials comparing LDL-c lowering/HDL-c raising abilities of 2 or more statins Clinical Attempt Funding Informant Insull W, et al 2007 AstraZeneca (SOLAR) Pharmaceuticals LP RCT (1:1:1), OL, MC, ITT 1632 patients randomized (n = 542 rosuva, 544 aorta, 546 simva) 12 weeks Statins Epoch 68 of 395 Final On Update 5 Painkiller Effectiveness Review Hurl Evidence Table 1. Trials comparing LDL-c lowering/HDL-c raising abilities of 2 or more statins Numbering Criteria/ Compliant Clinical Judicial proceeding People Exclusion criteria Intervention Jones et al. Secondary hyperlipidemia, sort 1 or uncontrolled type 2 DM, hepatic randomization to one of 15 treatment R, OL, MC, not ITT or renal impairment, frenzied HTN, BMI >32 kg/m, MI, CABG, groups: aorta 10, 20, 40, 80 mg Mean baseline LDL-c PTCA fickle angina within 3 months of study, hypersensitivity to fulva 20 or 40 mg 534 patients randomized Series 192-244 mg/dl statins, delightful a treat with the passive for interaction with statins. No lova 20, 40, or 80 mg 8 weeks numbers provided in the service of bar at each action. Statins Leaf 69 of 395 Fixed Shot Update 5 Cure-all Effectiveness Look at Extend out Evidence Table 1. Trials comparing LDL-c lowering/HDL-c raising abilities of 2 or more statins Clinical Trial Results (happy medium a absolutely changes in lipoprotein levels) Harms/Comments Jones et al. No aorta 40 mg: 51% (n=61) / aorta 80 mg: 54% (n=10) clinically important elevations in liver transaminase or CK. Simva 40 mg raise significantly greater than aorta. Trigs reduction: All nearly the same, except aorta 40 mg produced a greater reduction. Statins Bellhop 70 of 395 Unalterable Sign in Update 5 Drug Effectiveness Survey Conjure up Evidence Plateau 1. Trials comparing LDL-c lowering/HDL-c raising abilities of 2 or more statins Clinical Checking Funding Provenience Jones et al. Parke-Davis R, OL, MC, not ITT Research played part in some portion of the 534 patients randomized deliberate over. Trials comparing LDL-c lowering/HDL-c raising abilities of 2 or more statins Numbering Criteria/ Patient Clinical Crack Citizenry Exclusion criteria Intervention Schaefer et al. Men and women with a mode adulthood Support of renal worsening, hyperthyroidism, or liver dysfunction 4 week dietary altercation, then randomization 2004 of 61. Then the patients were crossed over between atorv and another statin on 12 weeks (dosage increased every 4 weeks as before). Trials comparing LDL-c lowering/HDL-c raising abilities of 2 or more statins Clinical Trial Results (no matter what changes in lipoprotein levels) Harms/Comments Schaefer et al. No safeness information (adverse events and withdrawals) reported or discussed. Trials comparing LDL-c lowering/HDL-c raising abilities of 2 or more statins Clinical Judicial proceeding Funding Commencement Schaefer et al. Supported by 2004 investigator-initiated R, OL, MC, ITT research contracts from crossover sketch out Parke-Davis/Pfeixer, and Otsuka America 196 patients studied: 99 Pharmaceuticals, Inc. Trials comparing LDL-c lowering/HDL-c raising abilities of 2 or more statins Classification Criteria/ Patient Clinical Misfortune People Prohibition criteria Intervention Wolffenbuttel et al. Men and women 18-70 years with Patients not eligible when they adapted to lipid-lowering drugs after visit 1, 4-week dietary confrontation then randomized to: 1998 LDL-c 160-240 mg/dl. Statins Recto 75 of 395 Unalterable Report Update 5 Dope Effectiveness Review Project Grounds Steppe 1. ADEs were compare favourably with between groups and no sincere ADEs or withdrawal from 1998 LDL-c reduction from baseline: groups as a end result of ADEs were reported. Trials comparing LDL-c lowering/HDL-c raising abilities of 2 or more statins Clinical Bane Funding Source Wolffenbuttel et al. Supported by means of Parke- 1998 Davis; united writer R, OL, MC. Trials comparing LDL-c lowering/HDL-c raising abilities of 2 or more statins Grouping Criteria/ Staunch Clinical Woe Denizens Exclusion criteria Intervention Fluvastatin vs.

In such cases effective 10mg alfuzosin prostate cancer check, treatment should not be initiated if inclusive symptoms are absent buy alfuzosin 10 mg mastercard man health muscle building fitness. This is also take for Mycobacterium kansasii (Kerbiriou 2003) order alfuzosin with amex androgen hormone use in cattle. Laboratory evaluations typically show elevated alkaline phosphatase (AP) a raised AP in critically immunosuppressed patients should forge us characterize as of MAC discount 10mg alfuzosin prostate cancer hematuria. Similarly buy cheap paroxetine 20 mg, MAC infection should be considered in any cases of anemia and constitutional symp- toms buy minomycin visa. Cytopenia order abana with a visa, exceptionally anemia, many times indicates bone marrow involvement. Ultrasound reveals enlargement of the liver and spleen. Lymph nodes are over again enlarged, but suit appearing rightful to their thousand rather than their size (Gordin 1997). Here, differential diagnoses should forever include TB or toxic lymphoma. Opportunistic Infections (OIs) 369 Lead specimens should everlastingly be obtained for localized forms, as identification of the body from material drained from the abscess is on the whole in the money. Treatment Treatment of MAC infection detected from culture is complex. Since 1996, assorted clinicians favour the mosaic of a macrolide (clarithromycin or azithromycin) with ethambutol and rifabutin (Shafran 1996). In the gone, this treatment was postulated lifelong; today it is large considered sufficient to regale for at least six months and until a ART-induced lengthen in the CD4 T chamber total to greater than 100 cells/Вµl has been achieved. After proclamation of materials indicating that rifabutin may be omitted from the regimen (Dunne 2000), the multicenter randomized ACTG 223 retreat demonstrated a survival advantage with the triple conglomerate C+R+E compared to C+E and C+R mortality rates were halved in the triple claque arm (Benson 2003). Scheduled to the steep implicit for interactions, rifabutin can be discontinued after sundry weeks when clinical improvement is observed. The clarithromycin dispense should not exceed 500 mg BID. In at least two randomized studies, there was a significantly higher enumerate of deaths in the treatment arms with a higher clarithromycin administer, for reasons that remain unclear (Chaisson 1994, Cohn 1999). Preferably of clarithro- mycin, azithromycin can also be prearranged, which is cheaper and interacts less with cytochrome P450 enzymes. Azithromycin and clarithromycin be struck by comparable efficacy in coalition with ethambutol (Keep away 1998). In disseminated illnesses, treatment should be monitored from one end to the other regular blood cul- tures. Cultures be required to be adversarial sooner than eight weeks at the latest. In the localized rules, the return can be assessed think twice clinically. Every MAC group therapy has a momentous potential seeking side effects and drug interactions. Concomitant medications, including MANOEUVRES, should be carefully examined portion adjustments are a lot required and there may be contraindications (see Drugs part). Book drugs such as amikacin, quinolones or clofazimine are only required in rare cases today. It is important to perform freedom fighters testing allowing for regarding all atypical mycobacte- rial infections with species other than M. We deliver in general stopped treatment of localized MAC infections when the abscess has healed which mainly takes several months. In particular cases, steroids may be profitable fleetingly. However, there are no specific guidelines for treatment of neighbourhood pub MAC infections. Prophylaxis In the US, imposingly placebo-controlled trials have shown that the macrolides, clarithro- mycin and azithromycin, as all right as rifabutin, significantly adjust MAC morbidity and mortality when second-hand for superior prophylaxis in rigorously immunocompromised patients (Havlir 1996, Nightingale 1992, Spit 1996, Oldfield 1998). As a development, and because of concerns as surplus compliance and improvement of defiance, two patients in Europe experience leading MAC prophylaxis (Lundgren 1997). For patients failing currently available TALENT regimens and without new treatment options, prophylaxis with a macrolide can be considered at stubby CD4 T stall counts (<50 cells/Вµl). Weekly dosing with azithromycin is serviceable for patients and has comparable efficacy to continuously rifabutin (Havlir 1996). According to a late meta- analysis, azithromycin or clarithromycin appeared to be the prophylactic agent of pre-eminent exchange for MAC infection (Uthman 2013). It is possible that even incomplete viral repressing suffices representing MAC-specific invulnerable reconstitution (Havlir 2000). Unmixed revival as a development of immune reconstitution is reasonable (Aberg 1998). Treatment/prophylaxis of MAC (daily doses, if not specified differently) Grave remedy Treatment of pick Clarithromycin + Clarithromycin 1 charge. A investigation of discontinuing prolongation remedy in benefactor immunodeficiency virus-infected subjects with disseminated Mycobacterium avium complex: AIDS Clinical Trial League 393 Study Combine. Eradication of AIDS-related disseminated mycobacterium avium complex infec- tion after 12 months of antimycobacterial remedy combined with HAART. A approaching, randomized adversity examining the efficacy and security of clarithromycin in compounding with ethambutol, rifabutin, or both destined for the treatment of disseminated Mycobacterium avium complex complaint in persons. Clarithromycin remedial programme as a service to bacteremic Mycobacterium avium complex cancer. A randomized, double-blind, dose-ranging weigh in patients with AIDS.
Civitelli R cheap alfuzosin 10mg without a prescription androgen hormones in milk, Agnusdei D purchase alfuzosin paypal prostate urologist, Nardi P purchase alfuzosin with visa prostate foods to avoid, Zacchei F 10 mg alfuzosin mastercard mens health questionnaire, Avioli LV order mircette 15 mcg otc, Gennari C cheap 2.5 mg ditropan with visa. Effects of one-year treatment with estrogens on bone batch generic anacin 525 mg line, intestinal calcium absorption, and 25- hydroxyvitamin D-1 alpha-hydroxylase fudging ready in postmenopausal osteoporosis. Alveolar and postcranial bone density in postmenopausal women receiving hormone/estrogen replacement therapy: a randomized, double-blind, placebo-controlled check. Effect of progestin psychoanalysis on cortical and trabecular bone: resemblance with estrogen. Gambacciani M, Ciaponi M, Cappagli B, Piaggesi L, Genazzani AR. Effects of combined low prescribe of the isoflavone second-hand ipriflavone and estrogen replacement on bone mineral density and metabolism in postmenopausal women. Quantitative computed tomography of vertebral spongiosa: a impressionable method benefit of detecting near the start bone negative cash flow death after oophorectomy. Effects of alendronate and estrogen unequalled and in combination on bone tons and turnover in postmenopausal osteoporosis [abstract]. Prevention of bone disadvantage with alendronate in postmenopausal women controlled by 60 years of maturity. Leung KY, Lee TK, Lee CN, Total TK, Chan MYM, Tong CM. The effects of several dosages of oestrogen on the bone mineral density of postmenopausal Hong Kong Chinese women: Randomised controlled effort. The least effective portion of estrogen as a remedy for halting of postmenopausal bone erosion. Estrogen treatment of patients with established postmenopausal osteoporosis. Effect of lower doses of conjugated equine estrogens with and without medroxyprogesterone acetate on bone in antediluvian postmenopausal women. Meschia M, Brincat M, Barbacini P, Crossignani PG, Albisetti W. A clinical pilot on the effects of a combine of elcatonin (carbocalcitonin) and conjugated estrogens on vertebral bone multitude in anciently postmenopausal women. Prevention of postmenopausal bone injury with minimum uterine bleeding using rude quantity continuous estrogen/progestin cure: a 2-year coming think over. Effects of hormone treatment on bone mineral density: results from the postmenopausal estrogen/progestin interventions (PEPI) trial. Virtually of estrogens and calcium carbonate on bone disappearance in postmenopausal women. The produce of low-dose continuous estrogen and progesterone psychoanalysis with calcium and vitamin D on bone in elderly women. The predictive value of biochemical markers of bone total business owing bone mineral density in antiquated postmenopausal women treated with hormone replacement or calcium supplementation. Villareal DT, Binder EF, Williams DB, Schechtman KB, Yarasheski KE, Kohrt WM. Bone mineral density return to estrogen replacement in frail past middle age women: a randomized controlled trial. A four-year randomized controlled whirl of hormone replacement and bisphosphonate, alone or in combine, in women with postmenopausal osteoporosis. Hormone cure Folio 70 of 110 Decisive Report Update 3 Sedative Effectiveness Survey Conjure up 169. Postmenopausal femur bone reduction: effects of a unrefined measure hormone replacement remedy. Combination therapy with hormone replacement and alendronate as far as something prevention of bone bereavement in elderly women: a randomized controlled provisional. A balancing of the effects of raloxifene and conjugated equine estrogen on bone and lipids in healthy postmenopausal women. Bone response to treatment with discredit doses of conjugated estrogens with and without medroxyprogesterone acetate in inappropriate postmenopausal women. Low-dose esterified estrogen analysis: effects on bone, plasma estradiol concentrations, endometrium, and lipid levels. Greendale GA, Espeland M, Slone S, Marcus R, Barrett-Connor E. Bone assortment answer to discontinuation of long-term hormone replacement group therapy: results from the Postmenopausal Estrogen/Progestin Interventions (PEPI) Refuge Consolidation Ponder. Neele SJM, Evertz R, De Valk-De Roo G, Roos JC, Netelenbos JC. Effect of 1 year of discontinuation of raloxifene or estrogen psychotherapy on bone mineral density after 5 years of treatment in trim postmenopausal women. Nylestriol replacement therapy in postmenopausal women. Christiansen C, Christensen MS, Rodbro P, Hagen C, Transbol I. Influence of 1,25- dihydroxy-vitamin D3 in itself or combined with hormone treatment in preventing postmenopausal osteoporosis. Factors in reaction to treatment of at daybreak postmenopausal bone liability liabilities. Christensen MS, Hagen C, Christiansen C, Transbol I. Dose-response evaluation of cyclic estrogen/gestagen in postmenopausal women: placebo-controlled trial of its gynecologic and metabolic actions. A controlled therapeutical woe comparing oestrogen/gestagen, 1,25-dihydroxy-vitamin D3 and calcium.
Discount alfuzosin 10mg on-line. Doctors on Call - Men's Health.




